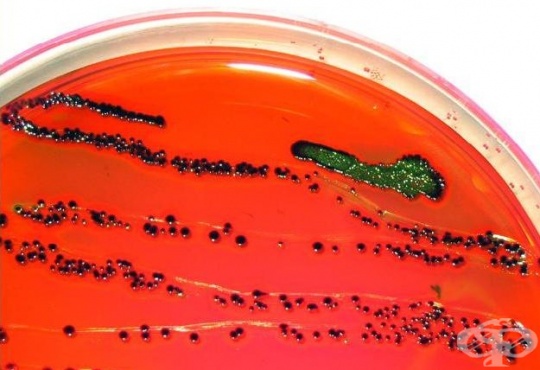
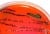

- Какво представлява циститът?
- Колко често се среща циститът?
- Какви видове цистит има?
- Какви са причините за цистита?
- Рискови фактори за цистит
- Заразен ли е циститът?
- Има ли определена сезонност на обостряне на цистита?
- Симптоми при цистит
- Как се поставя диагноза при цистит?
- Диференциална диагноза при цистит
- Кога да потърсите лекар при симптоми на цистит?
- Как се лекува циститът?
- Какви са усложненията при цистит?
- Каква е профилактиката при цистит?
- Прогноза при цистит
- Цистит след полов акт
- Цистит при мъже
4. Какви са причините за цистита?

Циститът се причинява най-често от бактериална инфекция. Над осем на всеки 10 случая на цистит се причиняват от бактерията Escherichia coli (Е. coli), която обикновено живее безвредно в червата. Съществува и редица други причини за поява на възпаление на пикочния мехур.
По-чести причини за цистит влючват:
- Инфекция на пикочните пътища
- Прием на някои лекарства
- Лъчелечение
- Чуждо тяло в пикочните пътища
- Употреба на някои продукти за интимна хигиена и контрацепция
- Някои медицински състояния
4.1. Инфекция
Циститът се причинява най-често от бактерии E. coli. Други чревни бактерии (Proteus, Klebsiella, Enterococcus) и стафилококовите микроорганизми (от кожата) също могат да доведат до развитие на цистит. Видът патоген, причиняващ инфекцията, може да варира в зависимост от възрастта на индивида. Например, Staphylococcus saprophyticus, кожна бактерия, причинява приблизително 10% от симптоматичните инфекции на пикочния мехур при млади сексуално активни жени, докато рядко причинява инфекции на пикочния мехур при мъже и възрастни хора.
Най-честата причина за цистит е инфекция с чревни бактерии, особено при жените, които имат анатомично по-къса уретра. Тази анатомична особеност предразполага към по-лесно достигане и проникване на бактериите, размножаващи се в областта на външните полови органи и ануса, до близко намиращата се женска уретра и пикочен мехур.
Урината е стерилна, т.е. в нея нормално няма бактерии. От друга страна е възможно да има бактерии в пикочния мехур на пациента без той да има оплаквания, особено в напреднала възраст.
Причините за инфектиране на пикочния мехур могат да бъдат разнообразни. При определени заболявания в пикочния мехур остава т.нар. остатъчна урина - известно количество урина, оставащо след уриниране. Това благоприятства размножаването на бактериите в пикочния мехур. Уретрата при жените може да се инфектира поради близостта й до ануса и входа на влагалището - в тях нормално има болестотворни и неболестотворни бактерии. След инфектирането на уретрата бактериите могат да бъдат унищожени от локалните защитни сили на лигавицата или да се разпространят нагоре до пикочния мехур, което да стане причина за цистит
Бактериите могат да попаднат в пикочните пътища по много начини и да причинят инфекция. За по-честото и лесно инфектиране на пикочния мехур оказват влияние:
- По време на полов акт - бактериите могат да попаднат в пикочния мехур при секс. „Цистит на медения месец“ - така се нарича циститът при жените, свързан с повишена сексуална активност. Дефлоративен цистит се наблюдава при някои момичета след първия им сексуален акт. Нормално по кожата в гениталната област има бактерии и поради близостта на уретрата до влагалището по време на полов акт могат да попаднат бактерии в нея. Препоръчва се уриниране на жените след полов контакт, за да може да се „отмият“ бактериите, които са попаднали в уретрата и да се предотврати тяхното попадане и размножаване в пикочния мехур.
- Лоша или неподходяща хигиена - бактериите могат да преминат от ануса към уретрата, особено ако има чревна инконтиненция. Интимната хигиена е изключително важна при жените и момичетата, тъй като уретрата им е по-къса от тази на мъжете и е разположена в близост до ануса. Измиването на гениталната област (ануса и външните полови органи) при тях трябва да бъде отпред-назад, за да се избегне пренасянето на бактерии от ануса към уретрата. Както ниската лична хигиена, така и прекомерната хигиена с употребата на дезинфектиращи сапуни може да е предразполагащ фактор за развитие на цистит. Необходимо е да се сменят често дамските превръзки и тампоните, за да се предпазят жените от цистит. Добре е да се избягва носенето на тясно бельо, особено на прашки, които се врязват в кожата и са едни от виновниците за пренос на бактерии от ануса към влагалището и уретрата.
- Дехидратация - прием на недостатъчно течности води до по-рядко уриниране, така че урината престоява в пикочния мехур по-дълго и може да доведе до растеж на бактерии. Намалява и чисто механичното отмиване на бактериите от пикочния мехур и уретрата и те имат много повече време да се размножават.
- Бременност - нарастващата матка може да притисне пикочния мехур, предотвратявайки пълното му изпразване и води до задържане на урина. Това може да увеличи риска от растеж на бактерии в пикочния мехур. Други предразполагащи фактори при бременните са промените в хормоналния баланс и променената обичайна микрофлора на влагалището. При бременните жени трябва да се правят профилактични изследвания на урината, тъй като дори и без симптоми (при 20-40% от бременните може да имат дискретни или липсващи симптоми) може да се наблюдава инфекция на пикочните пътища. При установяване на бактерии трябва да се проведе лечение, тъй като съществува риск за възникване на усложнения - инфекция на бъбреците (пиелонефрит) и преждевременно раждане.
- Диабет - при пациентите със захарен диабет бактериалната флора на кожата и лигавиците е променена. Освен това ако урината съдържа повече захар от обикновено, това може да стимулира растежа на бактерии в пикочния мехур и уретрата. Захарта в урината е идеална хранителна среда за бактериите.
- Менопауза - ниските нива на естроген могат да доведат до изтъняване на стената на уретрата и до по-кисела урина. Това може да увеличи податливостта към цистит.
- Наличие на катетър (тръба, която се поставя в уретрата за оттичане на урина от пикочния мехур) - при определени състояния е необходимо продължително използване на уретрален катетър, което е предпоставка за по-лесното проникване на бактерии в пикочния мехур и увеличава вероятността за инфектирането му и възникване на цистит.
- Контрацепция - използването на диафрагма или покрити със спермициди презервативи може да доведе до по-голяма вероятност от развитие на цистит. Диафрагмата може да предотврати пълното изпразване на пикочния мехур.
- Камъни в отделителната система - като камъни в бъбреците или камъни в пикочния мехур. Те могат да причинят обструкция, вследствие на която да се натрупва урина в пикочния мехур.
- Увеличена простата - затруднява изпразването на пикочния мехур, като след уриниране в мехура остава т.нар. остатъчна урина, която е благоприятна среда за размножаване на бактерии.
- Състояния, които влияят върху структурата на пикочните пътища - вродените аномалии на отделителната система също могат да се окажат причина за цистит. Някои от вродените аномалии на пикочните пътища се проявяват със симптоми на повтарящи се инфекции на пикочния мехур или бъбреците, особено при момчета и млади мъже поради препятствие в нормалното изпразване на пикочния мехур.
Гъбичните инфекции на пикочния мехур са много по-рядко срещани от бактериалните инфекции. Candida е най-честата гъбичка, която причинява инфекция на пикочния мехур. Инфекции на пикочния мехур от Candida могат да се появят при пациенти, чиято имунна система е отслабена, индивиди на лечение с мощни антибиотици за други инфекции, и лица, които са с постоянен пикочен катетър.
Вирусите рядко могат да причинят инфекции на пикочния мехур. Вирусен цистит може да се появи при лица след трансплантация на костен мозък и при други имунокомпрометирани индивиди.
4.2. Неинфекциозни причини
Възпалението на пикочния мехур може да се дължи и на инфекциозна етиология.
По-чести неинфекциозни причини за цистит включват:
- Някои медицински състояния - циститът може да се развие като усложнение на други заболявания като рак на половите органи, тазово-възпалителна болест, ендометриоза, болест на Крон, дивертикулит, лупус еритематодес, туберкулоза, увреждания на гръбначния мозък.
- Употреба на иритативни продукти в интимната област - химикали в продукти за интимна хигиена, интимни спрейове, пяна за вана, спермициди могат да доведат до възпаление.
- Прием на някои медикаменти - употрена на някои лекарства, особено химиотерапевтични лекарства (циклофосфамид и ифосфамид), може да доведе до възпаление на пикочния мехур - причина за лекарствено-индуциран цистит.
- Лъчева терапия - радиационно лъчелечение на тазовата област може да причини възпалителни промени на пикочния мехур и развитие на радиационен цистит.
- Чуждо тяло в пикочните пътища - продължителната употреба на катетър може да доведе до бактериални инфекции и увреждане на тъканите, като и двете могат да доведат до възпаление.

Коментари към Цистит